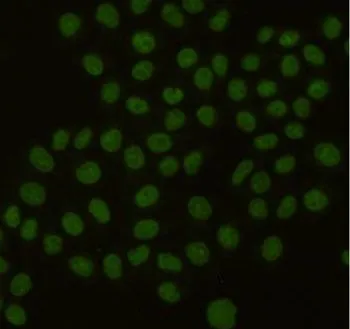

ICC/IF analysis of HeLa cells using PCNA antibody at a dilution of 1:100.
PCNA antibody [6B12-D7-H9]

GTX49256
ApplicationsImmunoFluorescence, ImmunoPrecipitation, Western Blot, ImmunoCytoChemistry
Product group Antibodies
ReactivityHamster, Human, Monkey, Mouse, Rat
TargetPCNA
Overview
- SupplierGeneTex
- Product NamePCNA antibody [6B12-D7-H9]
- Delivery Days Customer9
- ApplicationsImmunoFluorescence, ImmunoPrecipitation, Western Blot, ImmunoCytoChemistry
- CertificationResearch Use Only
- ClonalityMonoclonal
- Clone ID6B12-D7-H9
- ConjugateUnconjugated
- FormulationLiquid
- Gene ID5111
- Target namePCNA
- Target descriptionproliferating cell nuclear antigen
- Target synonymsATLD2; cyclin; DNA polymerase delta auxiliary protein; proliferating cell nuclear antigen
- HostMouse
- IsotypeIgG2b
- Protein IDP12004
- Protein NameProliferating cell nuclear antigen
- Scientific DescriptionThe protein encoded by this gene is found in the nucleus and is a cofactor of DNA polymerase delta. The encoded protein acts as a homotrimer and helps increase the processivity of leading strand synthesis during DNA replication. In response to DNA damage, this protein is ubiquitinated and is involved in the RAD6-dependent DNA repair pathway. Two transcript variants encoding the same protein have been found for this gene. Pseudogenes of this gene have been described on chromosome 4 and on the X chromosome. [provided by RefSeq, Jul 2008]
- ReactivityHamster, Human, Monkey, Mouse, Rat
- Storage Instruction-20°C or -80°C,2°C to 8°C
- UNSPSC12352203